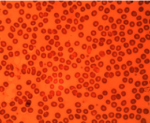

開発力・製造力・商社力 三つの力でお客様のご要望にお応えいたします
開発力・製造力・商社力 三つの力でお客様のご要望にお応えいたします

 |
 |
|
||||||||||
 |
 |
|||||||||||
| タイプA : 接眼鏡筒用 | タイプC : 3眼鏡筒用(C-マウント) | |||||||||||
|
||||||||||||
| 型番 | DCMOS01300KPA | DCMOS03100KPA | DCMOS05100KPA | DCMOS08000KPB |
| センササイズ | 1/3 インチ | 1/2 インチ | 1/2.5 インチ | 1/2.5 インチ |
| ピクセルサイズ(μm) | 3.6 x 3.6 | 3.2 x 3.2 | 2.2 x 2.2 | 1.67 x 1.67 |
| 応答性 | 2.1V/lux-sec | 1.0V/lux-sec | 0.53V/lux-sec | 0.31V/lux-sec |
| 有効画素数 | 1.3 MP | 3.0 MP | 5.0 MP | 8.0 MP |
| 最大解像度 | 1280 x 1024 | 2048 x 1536 | 2592 x 1944 | 3264 x 2448 |
| フレームレート | 15fps(1280 x 1024) | 8fps(2048 x 1536) | 5fps(2592 x 1944) | 1.9fps(3264 x 2448) |
| ビデオモード | 1280×1024 | 2048×1536 | 2592×1944 | 3264×2448 |
| 640×512 | 1024×768 | 1280×960 | 1600×1200 | |
| 320×256 | 680×510 | 640×480 | 800×600 | |
| ダイナミックレンジ | 44dB | 61dB | 66.5dB | 65.2dB |
| 波長 | 400~650nm (IRカットを追加) | |||
| 露光 | ERS (Electronic Rolling Snap) | |||
| ホワイトバランス | マニュアル/オート | |||
| オート露光 | マニュアル/オート | |||
| インタフェース | USB 2.0, 480Mb/s | |||
| パワーサプライ | USB 2.0, DC 5V/1.5A | |||
| プログラムコントロール | 画像サイズ、露出時間、明るさ、ゲイン、ガンマ補正、色、コントラスト、彩度 | |||
| 動作温度 | -30℃~70℃ | |||
| USBケーブル | USBケーブル(1.8m) | |||
| 付属品 | 2つのアダプタ(φ23.2~φ30、φ23.2~φ30.5、その他) TS-M1ステージ、マイクロメータ(オプションにて選択可) | |||
| 出力データ | RGB24、Direct Show、Twain | |||
| ソフトウェア | ドライバ : Direct Show、Twain イメージソフトウェア : ImageView 高度な画像処理ソフトウェア : ScopePhoto | |||
| システム | Windows XP/ 7/8/10 (32&64Bit) / OSx(Mac OS X) / Linux | |||
| 型番 | DCMOS09000KPB | DCMOS10000KPA | DCMOS14000KPA |
| センササイズ | 1/2.4 インチ | 1/2.3 インチ | 1/2.3 インチ |
| ピクセルサイズ(μm) | 1.67 x 1.67 | 1.67 x 1.67 | 1.4 x 1.4 |
| 応答性 | 0.31V/lux-sec | 0.31V/lux-sec | 0.724V/lux-sec |
| 有効画素数 | 9.0 MP | 10.0 MP | 14.0 MP |
| 最大解像度 | 3488 x 2616 | 3584 x 2748 | 4096 x 3288 |
| フレームレート | 1.9fps(3488 x 2616) | 1.9fps(3584 x 2748) | 1.8fps(1024 x 822) |
| ビデオモード | 3488×2616 | 3584×2748 | 4096×3288 |
| 1744×1308 | 1792×1374 | 2048×1644 | |
| 872×654 | 896×684 | 1024×822 | |
| ダイナミックレンジ | 65.2dB | 65.2dB | 65.2dB |
| 波長 | 400~650nm (IRカットを追加) | ||
| 露光 | ERS (Electronic Rolling Snap) | ||
| ホワイトバランス | マニュアル/オート | ||
| オート露光 | マニュアル/オート | ||
| インタフェース | USB 2.0, 480Mb/s | ||
| パワーサプライ | USB 2.0, DC 5V/1.5A | ||
| プログラムコントロール | 画像サイズ、露出時間、明るさ、ゲイン、ガンマ補正、色、コントラスト、彩度 | ||
| 動作温度 | -30℃~70℃ | ||
| USBケーブル | USBケーブル(1.8m) | ||
| 付属品 | 2つのアダプタ(φ23.2~φ30、φ23.2~φ30.5、その他) TS-M1ステージ、マイクロメータ(オプションにて選択可) | ||
| 出力データ | RGB24、Direct Show、Twain | ||
| ソフトウェア | ドライバ : Direct Show、Twain イメージソフトウェア : ImageView 高度な画像処理ソフトウェア : ScopePhoto | ||
| システム | Windows XP/ 7/8/10 (32&64Bit) / OSx(Mac OS X) / Linux | ||
お問い合わせはこちら